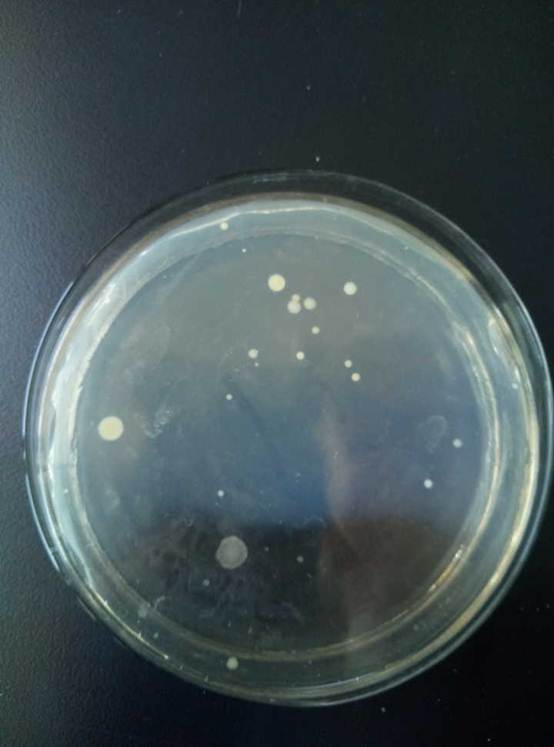

beats365官方网站青年志愿者协会成员合影

白龟湖采集样品

实验室微生物培养
(通讯员 李赫)3月22日,即世界水日,beats365官方网站青年志愿者协会结合专业特色抽取水样在实验室培养水样菌种数目和种类,检测水样污染状况,研究水中微生物以及有害菌,检测水样污染状况,以唤起广大师生的节水意识及水资源保护意识。
实验开始前,beats365官方网站青年志愿者协会向公司申请实验所需器材及场所,在平西湖随机五处取样。取样后培养水样菌种数目和种类,并通过研究水中微生物以及有害菌,预测水样污染状况。取得的样品用肉眼观测有少量泥土,用ph试纸检测呈现弱碱性,水质不能正常饮用,在显微镜下观察,有少量虫卵,但经过过滤后较为清澈,取过滤后水样不进行稀释检测,经过48小时培养,样品中微生物含量较少,参考《生活饮用水卫生标准》,可以得知经过处理的水,可以饮用。
通过此次活动,能够警醒师生们未经处理的水不宜饮用,倡导师生不要污染水源保护大自然,提醒人们应该通过自身行为来改变水质,让更多的水可以被我们使用。
beats365官方网站
2018年03月22日